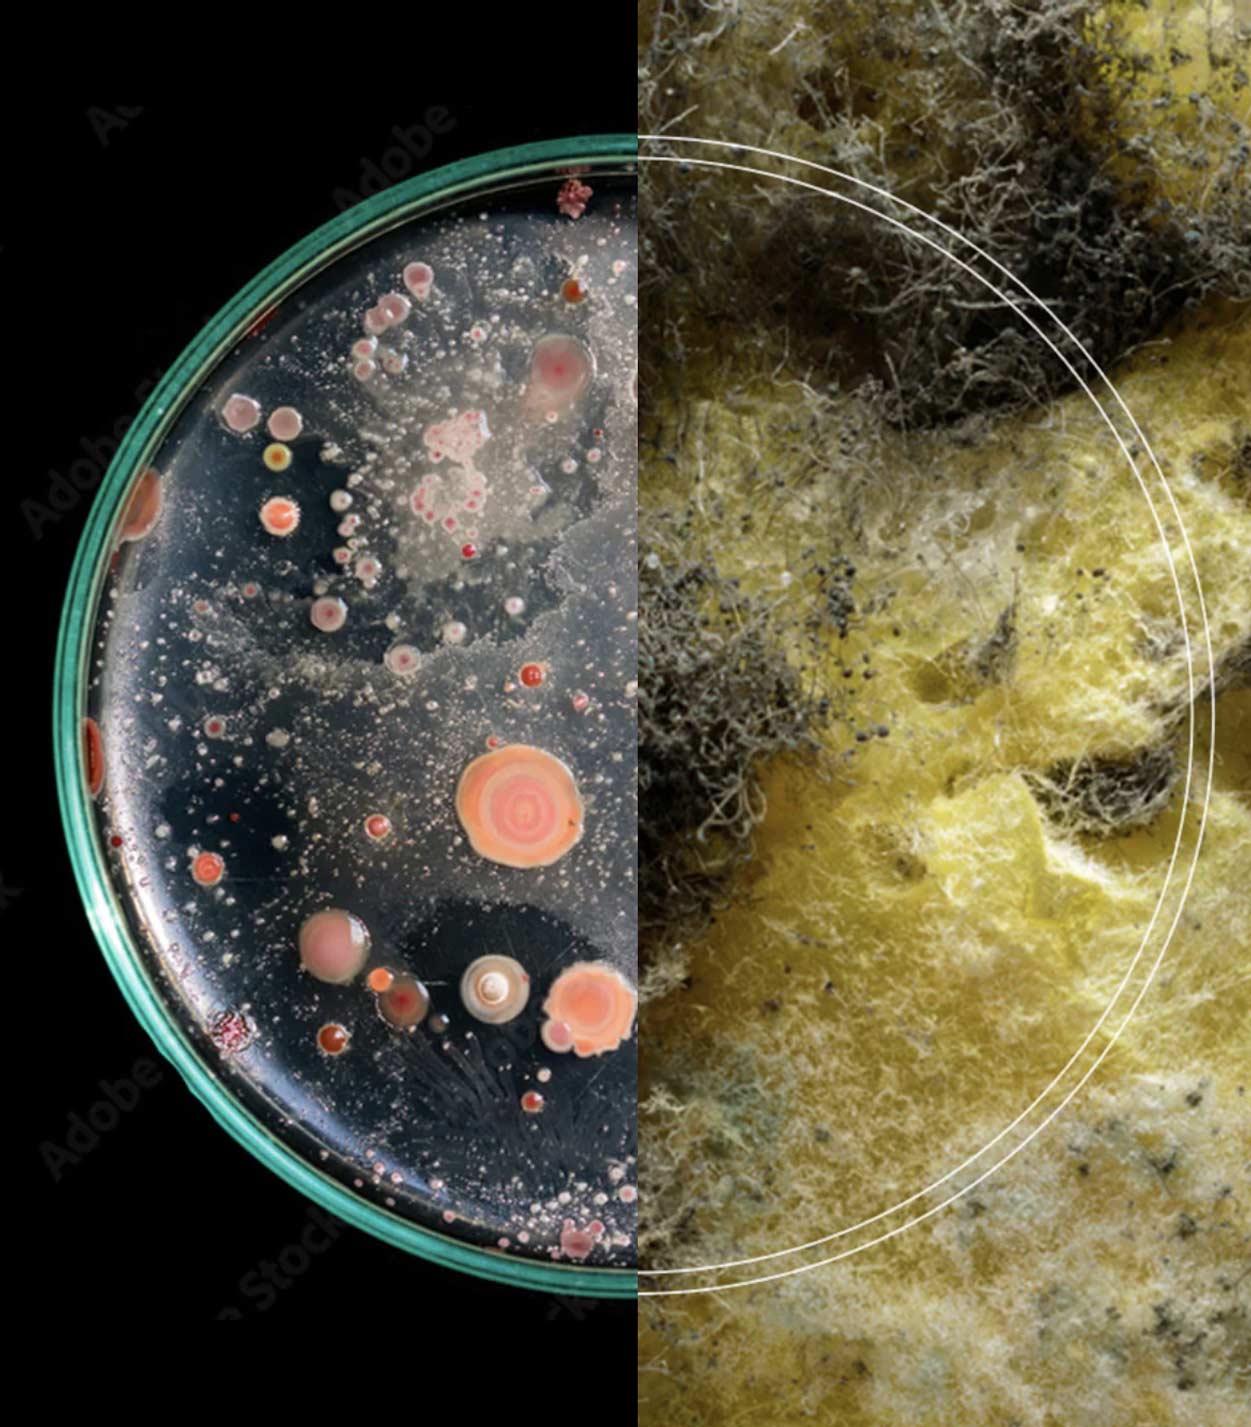
Background texture

We hear the word ‘biodegradable’ a lot.
It sounds complicated, but it’s really very simple. A product that is made from 100% plant-based, biodegradable materials can break down and back into nature without causing any harm.












The running shoe that you’re wearing today won’t biodegrade until your
great, great, great, great, great, great, great, great, great, great grandchild exists.
And if we don’t do something about that now, they won’t be very happy.
Landfills are home to hundreds of microbes. Under the right conditions, they consume our materials and release enzymes that break them down, making it easier for microorganisms to munch on the rest.


Liquidplant is on track to fully biodegrade in 3 years.
That’s 150x faster than petroleum-based materials, with no microplastics left behind!
*Testing per ASTM D5511. Results based on 300 micron sheet.
(And don’t forget to say thanks to a microbe, or an enzyme, or a microorganism next time you see one)

